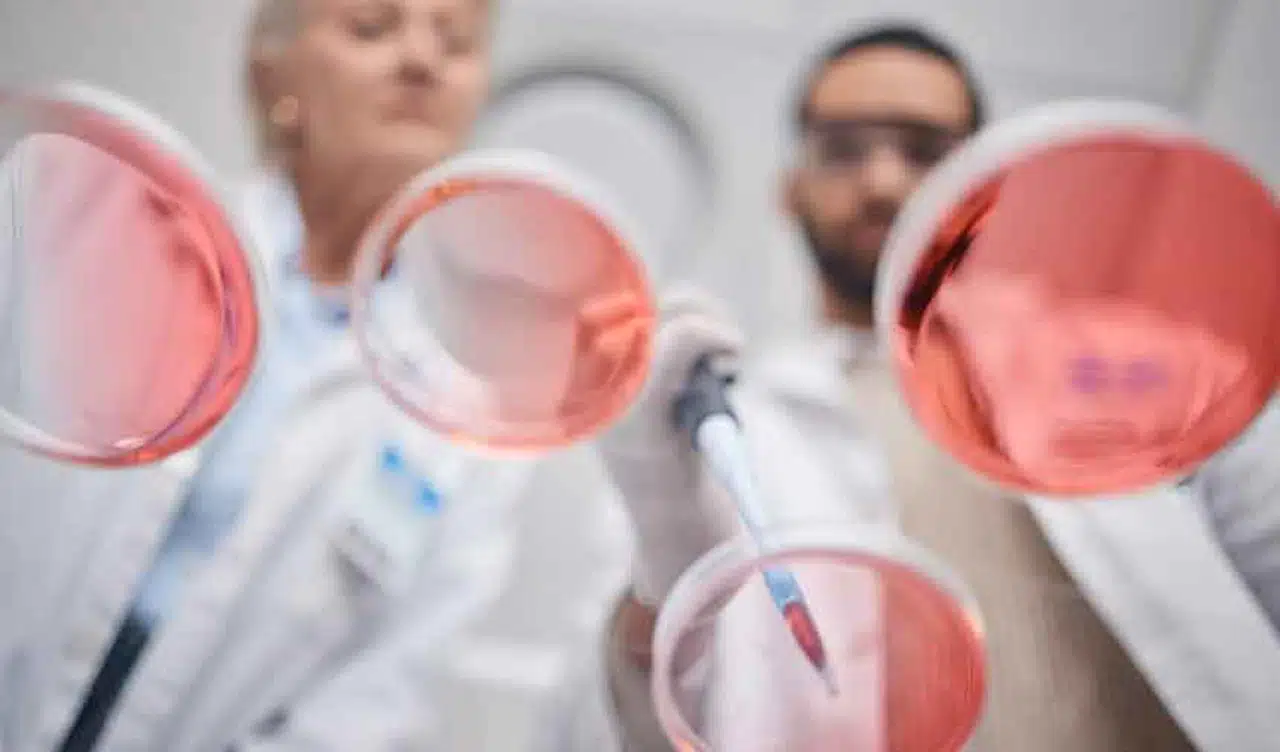

Patoloji Nedir? Temel Kavramlar ve İşlevleri
Patoloji, hastalıkların kökeni, gelişimi, nedenleri ve etkilerini inceleyen tıp bilim dalıdır. Vücutta meydana gelen anormal durumları ve bu durumların hücresel, doku ve organ düzeyindeki etkilerini araştırarak hastalıkların tanısının konulmasına katkıda bulunur. Tıbbın en önemli dallarından biri olan patoloji, laboratuvar temelli çalışmalarıyla birçok hastalığın teşhisini, tedavisini ve önlenmesini mümkün kılar.
Patolojinin temel amacı, vücutta meydana gelen anormallikleri incelemek ve hastalıkların nedenlerini belirlemektir. Bu süreç, hücresel ve dokusal değişikliklerin analiz edilmesi, biyopsiler ve otopsiler gibi yöntemlerin kullanılmasıyla gerçekleştirilir. Patologlar, hastalığın altında yatan nedenleri ve bu hastalığın vücut üzerindeki etkilerini anlamaya çalışarak tanıya yönelik önemli bulgular sunarlar.
Patolojinin Temel Kavramları
Patoloji, iki ana alt dala ayrılır: genel patoloji ve spesifik (özel) patoloji. Genel patoloji, hastalıkların temel prensiplerini ve hücresel süreçlerini anlamaya çalışırken, spesifik patoloji, belirli organ veya dokularda meydana gelen hastalıkları incelemektedir.
Hastalık: Vücudun normal işleyişinde meydana gelen bozulmalar ve anormal durumların genel adıdır. Hastalıklar genetik faktörlerden, enfeksiyonlardan, çevresel etkilerden veya bağışıklık sistemindeki bozukluklardan kaynaklanabilir.
Lezyon: Patolojik süreçlerin sonucunda meydana gelen doku veya organ hasarına lezyon denir. Lezyonlar, hastalığın bir göstergesi olarak değerlendirilir ve biyopsi veya otopsi ile incelenir.
Enflamasyon: Vücudun enfeksiyon, travma veya zararlı uyaranlara karşı verdiği bağışıklık tepkisidir. Enflamasyon, vücutta hasarın iyileşmesi ve enfeksiyonlarla savaşılmasında önemli bir rol oynar, ancak aşırı enflamasyon hastalıklara yol açabilir.
Nekroz: Hücrelerin ve dokuların hasar sonucu ölmesi durumudur. Nekroz, enfeksiyonlar, kimyasal hasar veya travma nedeniyle meydana gelebilir ve bu süreç hastalıkların gelişiminde kritik bir rol oynar.
Neoplazi: Hücrelerin kontrolsüz bir şekilde büyümesiyle ortaya çıkan tümör oluşumudur. Neoplazi, iyi huylu (benign) veya kötü huylu (malign) olabilir. Malign tümörler kanser olarak bilinir ve metastaz yaparak vücudun farklı bölgelerine yayılabilir.
Patolojinin İşlevleri
Patoloji, tıbbi tanı ve tedavi sürecinde çok önemli bir rol oynar. Patologlar, çeşitli testler ve analizler yardımıyla hastalığın altında yatan sebepleri bulur ve hastalığın seyrini anlamaya çalışır. Patolojinin başlıca işlevleri şunlardır:
1. Tanı Koyma
Patolojinin en temel işlevi, hastalıkların tanısının konulmasına yardımcı olmaktır. Biyopsi örneklerinin mikroskop altında incelenmesi, hastalığın tipi, evresi ve yayılma durumunun belirlenmesinde büyük önem taşır. Kanser gibi hastalıkların doğru teşhisi, tedavi sürecinin etkin bir şekilde planlanmasına olanak tanır.
2. Biyopsi ve Sitoloji
Biyopsi, vücuttan alınan küçük doku örneklerinin mikroskop altında incelenmesi işlemidir. Biyopsi, genellikle tümörlerin iyi veya kötü huylu olup olmadığını belirlemek için kullanılır. Sitoloji ise hücrelerin mikroskop altında incelenmesini ifade eder ve genellikle kanser taraması için kullanılır. Pap smear testi gibi yöntemler, sitolojiye örnek olarak gösterilebilir.
3. Otopsi
Otopsi, bir kişinin ölüm nedenini belirlemek için yapılan incelemeleri kapsar. Özellikle adli tıp alanında otopsiler, ölümlerin ardındaki nedenleri anlamak ve ölümle sonuçlanan hastalıkları analiz etmek için önemlidir. Otopsiler, aynı zamanda tıbbi hataları anlamada ve tedavi süreçlerini geliştirmede yardımcı olabilir.
4. Enfeksiyonların Tespiti
Patoloji, enfeksiyon hastalıklarının teşhisinde de kritik bir rol oynar. Vücutta bulunan mikroorganizmaların, virüslerin veya bakterilerin tanımlanması, bu patojenlerin neden olduğu hastalıkların teşhisi ve tedavisinde büyük önem taşır. Patologlar, kültür testleri ve mikroskopik incelemelerle enfeksiyonun türünü ve yayılma durumunu belirleyebilir.
5. Moleküler Patoloji
Moleküler patoloji, DNA ve genetik materyal üzerinde yapılan analizlerle hastalıkların nedenlerini daha derinlemesine anlamaya çalışır. Bu alanda yapılan çalışmalar, genetik mutasyonlar, kanser türleri ve kalıtsal hastalıkların teşhisi ve tedavisinde önemli ilerlemeler sağlamaktadır. Genetik testler, özellikle kişiselleştirilmiş tedavi yöntemlerinin geliştirilmesinde kullanılır.
Patolojinin Tıpta Kullanım Alanları
Patoloji, tıbbın birçok alanında önemli bir rol oynar. Başta kanser tanısı olmak üzere, patolojinin kullanım alanları oldukça geniştir:
Onkoloji: Kanserin teşhisi ve tedavi sürecinin planlanmasında patoloji kilit bir rol oynar. Tümör biyopsileri ve sitoloji testleri, kanser türünü ve evresini belirleyerek tedavi sürecinin yönlendirilmesine yardımcı olur.
Enfeksiyon Hastalıkları: Bakteri, virüs ve mantar enfeksiyonlarının tanısında patoloji laboratuvarları kritik görev üstlenir. Mikroorganizma tespiti, enfeksiyonun doğru şekilde tedavi edilmesini sağlar.
Dermatoloji: Cilt lezyonları ve deri hastalıklarının teşhisinde patolojik analizler yapılır. Özellikle cilt kanserlerinin tanısında biyopsi sonuçları büyük önem taşır.
Nöropatoloji: Sinir sistemi hastalıkları, beyin tümörleri ve nörodejeneratif hastalıkların tanısında patolojik incelemeler yapılır. Alzheimer, Parkinson gibi hastalıkların altında yatan yapısal değişiklikler, patoloji yardımıyla analiz edilir.
Sonuç
Patoloji, hastalıkların teşhisi ve tedavisi sürecinde vazgeçilmez bir tıp disiplinidir. Hücresel düzeyde yapılan incelemeler, hastalıkların nedenlerini anlamamıza ve etkili tedavi yöntemleri geliştirmemize olanak tanır. Patologlar, biyopsi, otopsi ve moleküler analizler gibi yöntemlerle hastalıkların tanısında kritik bir rol oynar. Bu disiplin, modern tıbbın hastalıklarla savaşında önemli bir bilimsel temel oluşturur.